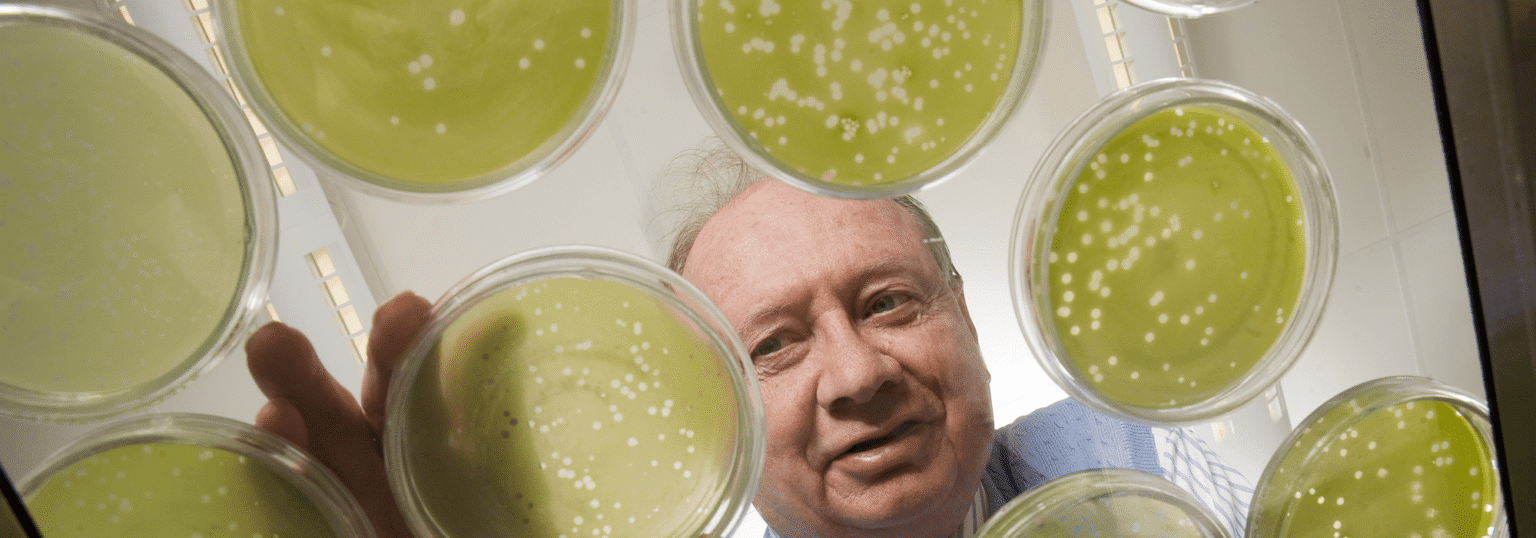
090226 Van Etten 167 e1414627907773 فيروس يؤدي إلى نقص الأداء الإدراكي لدى البشر مجلة نقطة العلمية

تبعاً لدراسة جديدة قام بها الباحثون في جامعة جونز هوبكنز وجامعة UNL))، فإن الحمض النووي لأحد الفيروسات التي كان يعتقد سابقاً بأنها تصيب خلايا الطحالب فقط، قد تكون في الواقع قادرة على غزو المملكة البيولوجية للفئران والإنسان، حيث أشار الباحثون الذين قاموا بنشر هذا البحث في 27 تشرين الأول في دورية الاكاديمية الوطنية للعلوم، أنه أثناء قيامهم بإجراء دراسة حول الأداء الإدراكي للإنسان، وجدوا في عينات مسح مأخوذة من حناجر أشخاص أصحاء، حمضاً نووياً يشابه الحمض النووي الموجود لدى نوع من الفيروسات تدعى (Chloroviruses) والتي تصيب الطحالب، ويمثل هذا الاكتشاف الحالة الأولى الموثقة لتواجد سلسلة جينية للـ (Chloroviruses) في تجويف حلق بشري.
بحسب مؤلف الدراسة (جيمس فان إتين)، المدير المشارك لمركز نبراسكا لعلم الفيروسات، فإن فيروس ((Chloroviruses يعتبر من الفيروسات التي تنتشر بشكل واسع في جميع أنحاء العالم، فهي توجد لدى معظم الأحياء التي تعيش داخل المياه العذبة مثل البحيرات والبرك، ولكن مع ذلك فإنه من النادر حقاً أن تستطيع هذه الفيروسات الانتقال من مملكة معينة من الأحياء إلى أخرى، وإذا ما كان هذا الأمر صحيحاً، فستكون مفاجئة كبيرة في عالم الأحياء.
بعد انتهاء الباحثين من تقييم الدراسة الأصلية التي تتمحور حول الأداء الإدراكي، اكتشف الباحثون أن المشاركين الذين كانوا يحملون الحمض النووي الخاص بـ (chlorovirus) ، أو (ATCV-1) كان أداؤهم أسوأ في اختبارات المعالجة البصرية والتوجه المكاني من الأشخاص الذين لا يحملونه، وهذا يدل بحسب القائم على البحث (روبرت يولكن)، مدير مختبر ستانلي لعلم الفيروسات العصبية في جامعة جونز هوبكنز، أن الكائنات الحية الدقيقة “الحميدة” التي نحملها يمكن أن تؤثر على سلوكنا وإدراكنا، فعلى الرغم من أن معظم الاختلافات الفيزيولوجية لدى البشر تأتي نتيجة لوجود اختلافات في الجينات التي نرثها عن كل آبائنا وأمهاتنا، إلّا أن بعض هذه الاختلافات الفيزيولوجية تأتي أيضاً نتيجة لتواجد الكائنات الحية الدقيقة المختلفة داخلنا، حيث تؤثر هذه الكائنات علينا من خلال الطريقة التي تتفاعل فيها مع جيناتنا.
للتأكد من عدم وجود احتمال لتأثير عامل ثالث مجهول يؤثر على العلاقة بين (ATCV-1) والعجز المعرفي، قام الفريق بتقييم آثار chlorovirus)) على الفئران، وقد بينت النتائج أن القوارض التي تم تلقيحها بهذا الفيروس أظهرت عجزاً مماثلاً في الذاكرة المعرفية وفي التركيز أثناء التنقل خلال المتاهات، كما بينت النتائج أيضاً أن وجود فيروس (ATCV-1) أدى لحصول تغير في طريقة عمل أحد الجينات الموجودة في الدماغ وتحديداً في منطقة تلفيف الحصين عند القوارض، وهي المنطقة الدماغية المرتبطة بالذاكرة والتنقل المكاني.
بحسب (فان إتين)، فإن فيروس (ATCV-1) والعديد من الفيروسات الأخرى من هذا النوع تحدث تغيّراً في حوالي 400 جيناً، وهذا العدد أكبر بحوالي 40 مرة من التغيرات التي تحدثها الفيروسات المعروفة، مثل فيروس نقص المناعة البشرية والأنفلونزا، إلا أن كبر حجم هذه الفيروسات، إلى جانب ندرة انتقالها من مملكة إلى أخرى، ساهم كثيراً في تجاهل تأثيرها على البشر، فعلى الرغم من أنه تم إجراء العديد من الدراسات فيما سبق للبحث عن الفيروسات والبكتيريا في مسحات الحلق التقليدية، إلا أن الطريقة التي تتم فيها إجراء تلك الدراسات أدت إلى التغاضي عن الفيروسات التي تصيب الطحالب، كون الباحثين عادةً ما يقومون بإجراء استبعادات للفيروسات عندما يجرون دراسة عن الفيروسات التي تصيب البشر، وغالباً ما تتم التصفية على أساس الحجم، فالنظرة التقليدية للفيروسات تشير إلى أن حجمها يجب أن يكون صغيراً جداً، لذلك تم استبعاد فيروسات الـ ((chloroviruses نظراً لحجمها الكبير.
أخيراً فإن (فان إتين) وفريقه يقومون حالياً بدراسة إمكانية قيام هذا الفيروس بنسخ نفسه داخل الخلايا البشرية، بالإضافة لإجراء المزيد من الدراسات للتأكد من نتائج هذا البحث.